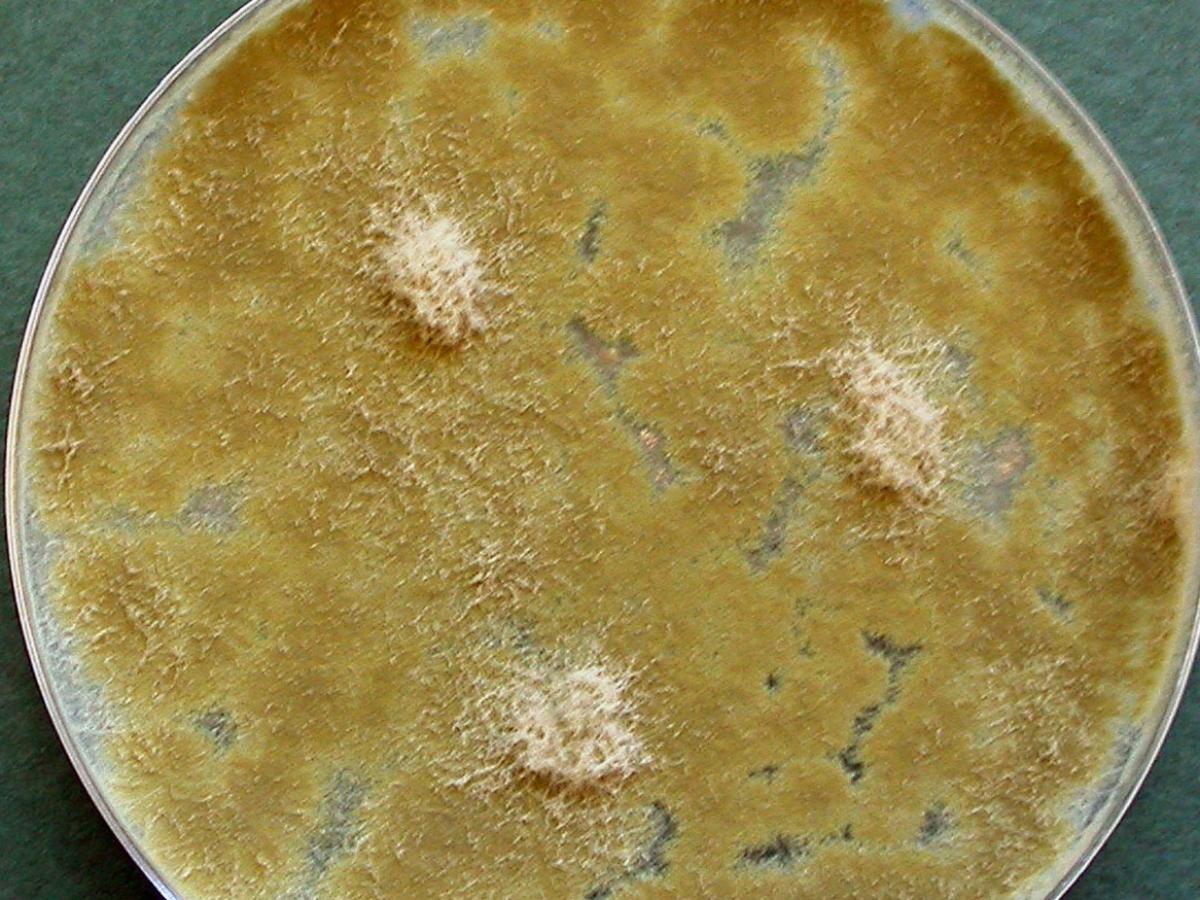
Culture

Status message
Correct! Excellent, you have done well. Please find additional information below.
Unknown 1 = Paecilomyces variotii
Histopathology: Methenamine silver stained tissue section showing branched, septate hyphae.

Culture: Colonies are fast growing, powdery to suede-like and yellow-brown or sand coloured.

Microscopy: Conidiophores bearing vertcillately arranged branches bearing phialides. Phialides are swollen at their bases, gradually tapering into a rather long and slender neck. Conidia are single-celled or in short chains, ellipsoidal to fusiform, hyaline to yellow, 3-5 x 2-4 um and are produced in basipetal succession from the phialides.

Chlamydoconidia are usually present, singly or in short chains, brown, subspherical to pyriform, 4-8 um diam, thick-walled to slightly verrucose.

Comments: Paecilomyces variotii is a common environmental mould that is widespread in composts, soils and food products. It is known from substrates including food, indoor air, wood, soil and carpet dust. It is a causative agent of mycotic keratitis and of hyalohyphomycosis in the immunocompromised patient.
About Paecilomyces Back to virtual assessment